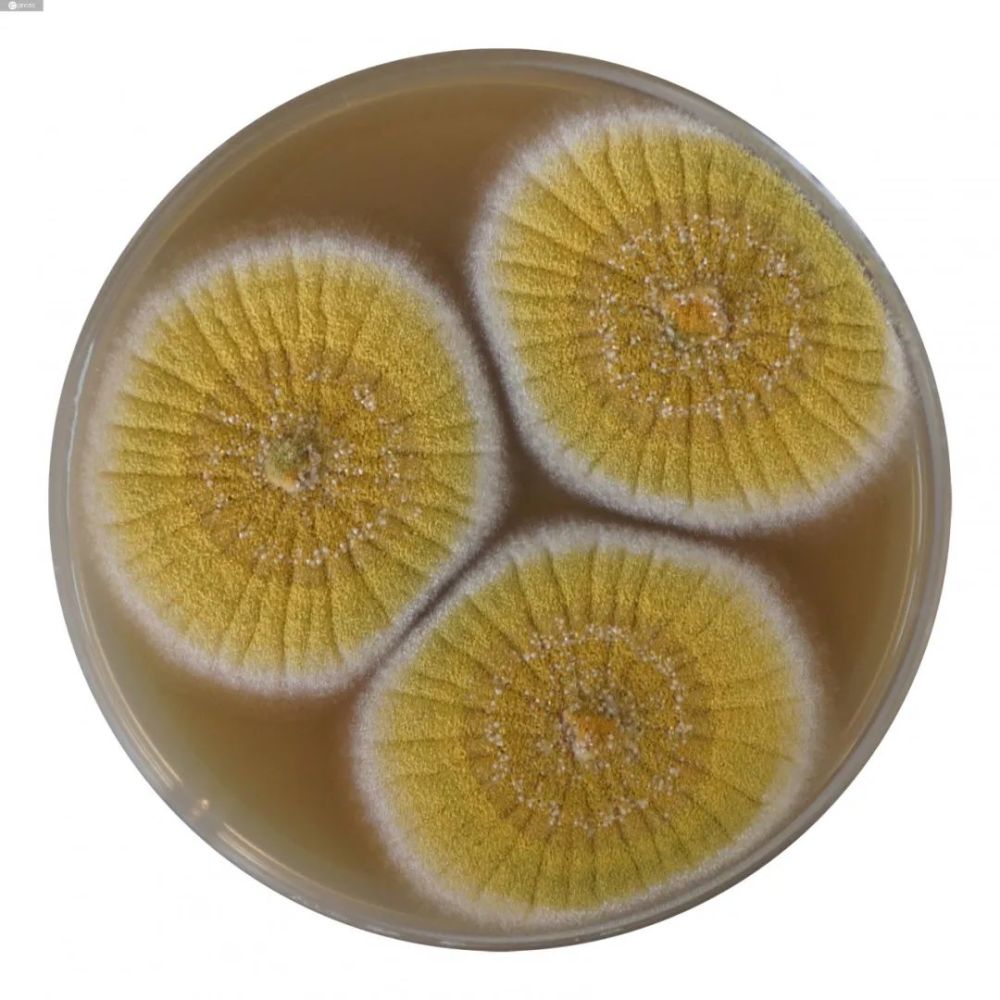
黄曲霉素

黄曲霉毒素购买

实验——食品净化器对黄曲霉毒素的降解
图片尺寸3508x2469
中药材出现黄曲霉毒素超标原因药材种植植物病害黄曲霉毒素及农残问题
图片尺寸711x435
(据研究表明:黄曲霉毒素是人类已知的最强的致癌物之一).
图片尺寸730x547
黄曲霉素1毫克可以致癌,20毫克能致命,这样的食物都有它|毒素|致癌物
图片尺寸640x375
霉菌毒素危害重重,应如何破解?|黄曲霉|仔猪|饲料_网易订阅
图片尺寸431x346
黄曲霉毒素生存地点
图片尺寸1080x720
比如下面这些:黄曲霉毒素最喜欢"藏"在发霉的食物里,尤其是淀粉含量
图片尺寸640x1079
发霉的花生含黄曲霉素,不仅有毒还致癌?医生:这6物,少碰为妙
图片尺寸500x334
辟谣|黄曲霉毒素能被煮死?一家9人死8人,警惕4种食物1个板
图片尺寸1200x800
黄曲霉毒素
图片尺寸1024x768
黄曲霉素
图片尺寸1000x1000
黄曲霉毒素对身体危害大吗或要引起注意
图片尺寸640x400
毒素黄曲霉b1分解霉菌降解生物脱霉剂饲料添加剂饲料脱霉剂
图片尺寸800x800
黄曲霉毒素(aft)是一类化学结构类似的化合物,均为二氢呋喃香豆素的
图片尺寸240x240
黄曲霉毒素检测,黄曲霉毒素检测方法有哪些?
图片尺寸700x526
黄曲霉毒素最早发现于1960年,是至今为止发现的毒性以及致癌性最强的
图片尺寸1080x755
饲料原料中黄曲霉毒素的脱毒处理方法
图片尺寸363x539
比砒霜还要毒68倍的黄曲霉毒素 - 简书
图片尺寸640x551
剂笔笔灯黄曲霉素紫光检测黄曲霉紫外线毒素检测荧光手电筒验钞菌
图片尺寸750x938
如何预防黄曲霉毒素(如何预防黄曲霉毒素对人体的危害?
图片尺寸1920x1080